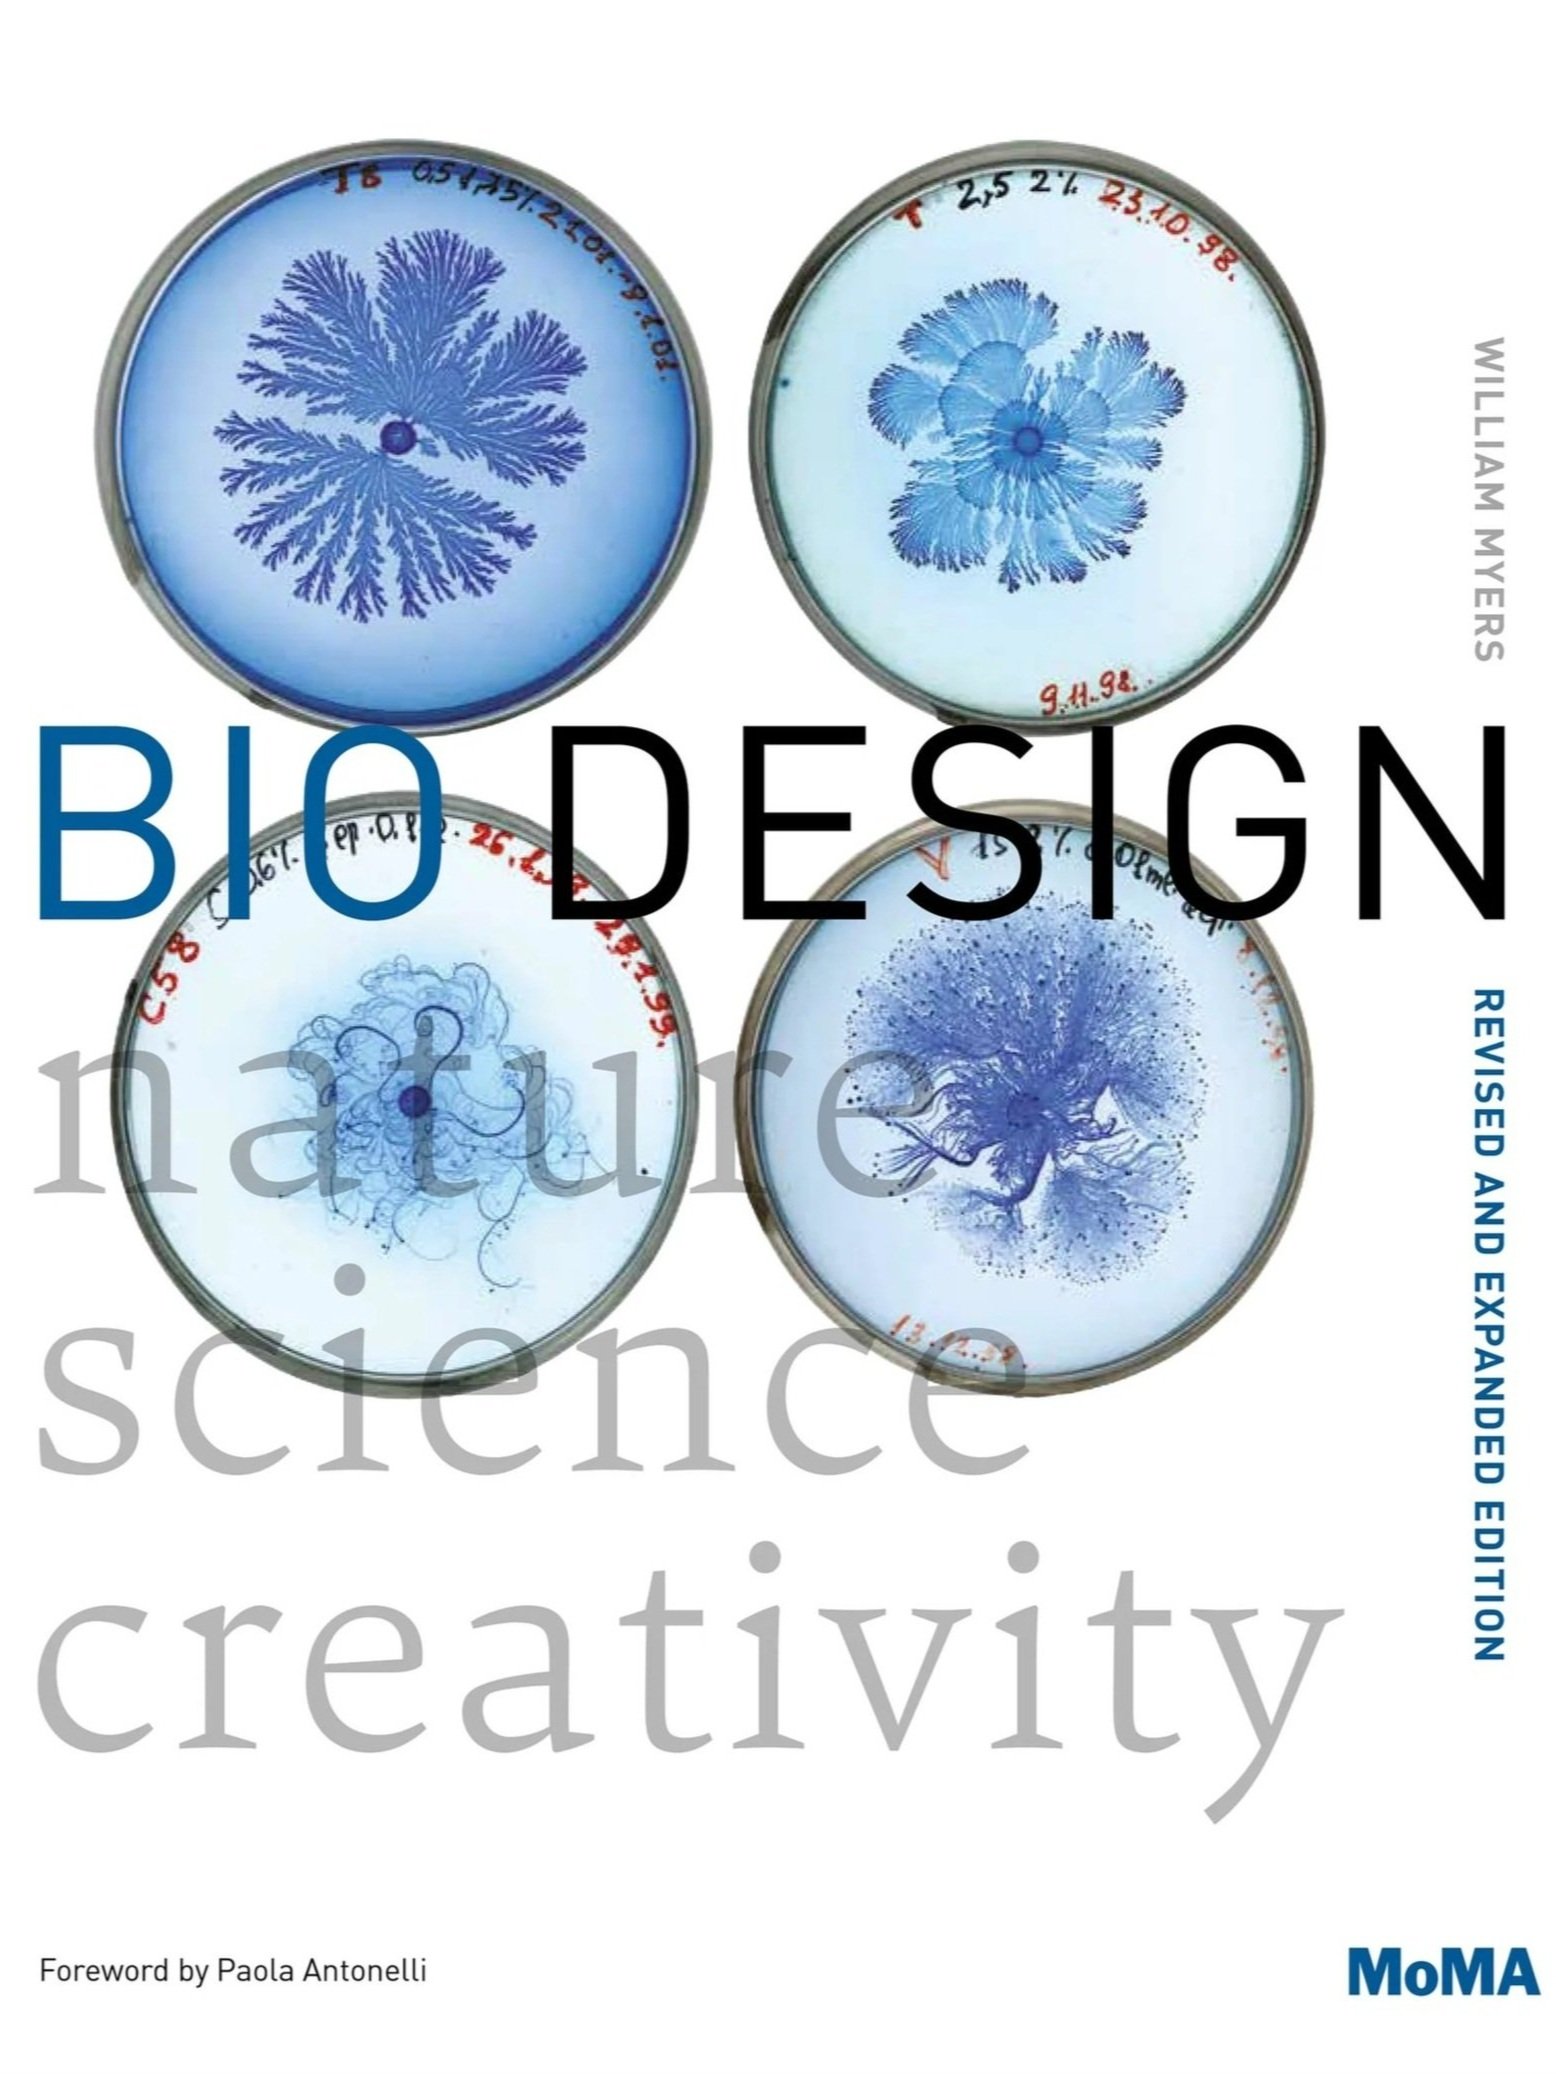

Bio Design: Nature + Science + Creativity,
William Myers, (2018)
Bio Design: Nature + Science + Creativity examines thrilling new ways in which biology is being applied outside the lab, showcasing some seventy projects that cover a range of fields—from architecture and industrial design to fashion and medicine. This revised and expanded edition celebrates the most innovative and often radical approaches to biological design in recent years, and includes 12 new projects, among them Hy-Fi by David Benjamin, a biodegradable tower; Guard from Above by Sjoerd Hoogendoorn, a company that trains birds of prey to intercept hostile drones; Zoa by Modern Meadow, the first biofabricated leather material brand; and Circumventive Organs by Agi Haines, which uses animal cells to print new types of organs. It also features a new how-to section with tips for collaboration between designers and scientists, FAQs and further resources, as well as a fully revised introduction.